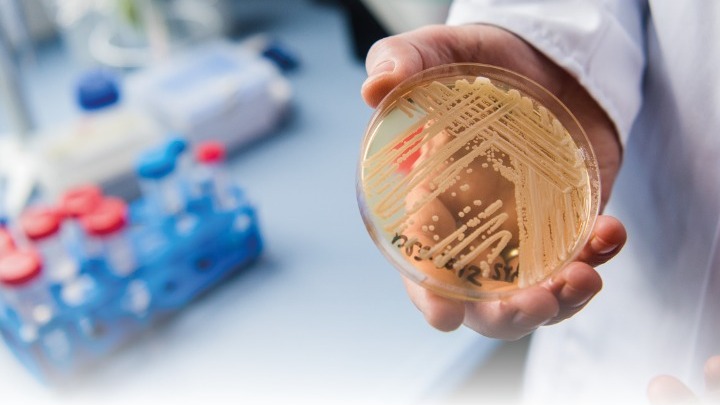

Τι είναι ο μύκητας Candida auris, που τον συνανταμε και πόσο πρέπει να ανησυχούμε; Απαντήσεις δίνει η Αριστέα Βελεγράκη καθηγήτρια Ιατρικής Σχολής ΕΚΠΑ, συστήνοντας ψυχραιμία και τήρηση των βασικών κανόνων υγιεινής.
Ο Candida auris, πρωτοαπομονώθηκε και ταυτοποιήθηκε σε ασθενή με μυκητίαση στο αυτί, στην Ιαπωνία το 2009. Όμως, αναδρομικές μελέτες έδειξαν ότι προϋπήρχε ως αίτιο σηψαιμίας από το 1996, αλλά δεν μπορούσε να αναγνωριστεί με τα τότε διαθέσιμα εργαστηριακά μέσα. Σύμφωνα με την κ. Βελεγράκη ,ο μύκητας Candida auris βρίσκεται σε νοσοκομειακούς χώρους αλλά και στην κοινότητα. Την τελευταία τριετία, τα προηγμένα συστήματα ανάλυσης που χρησιμοποιούν τα εξειδικευμένα μυκητολογικά εργαστήρια κάνουν ακόμη ευκολότερη την ταυτοποίηση του μύκητα. Αυτό έχει συνεισφέρει στην αύξηση της συχνότητάς του, που παρατηρείται τελευταία.
Δημοσιευμένες ή υπό δημοσίευση μελέτες από το Εργαστήριο Ερευνητικής Μυκητολογίας, της Ιατρικής Σχολής Αθηνών καταδεικνύουν ότι οι κλώνοι Candida auris, που απαντώνται συχνότερα στην Ελλάδα προέρχονται από την Ινδία και ακολουθούν αυτοί από την Αυστρία και το Κουβέιτ.
Πόσο επικίνδυνος είναι ο μύκητας Candida auris
Το παθογόνο συνιστά απειλή για τη Δημόσια Υγεία, διότι έχει την ικανότητα να αποικίζει εύκολα το δέρμα, να μεταδίδεται ταχέως από ασθενή σε ασθενή στο νοσοκομειακό χώρο και να προκαλεί λοίμωξη βαριάς πρόγνωσης, ιδιαίτερα σε ασθενείς με ανοσοκαταστολή.
Επιπλέον, παραμένει για αρκετό χρονικό διάστημα στις επιφάνειες αντικειμένων, ενώ κάποια απολυμαντικά δεν τον εξουδετερώνουν, αναφέρει η κ. Βελεγράκη. Κάποια στελέχη Candida auris εμφανίζουν αντοχή στα αντιμυκητιασικά φάρμακα, με αποτέλεσμα να γίνεται δύσκολη η θεραπεία της λοίμωξης.
Να ανησυχούμε;
Προς το παρόν δεν υπάρχουν στοιχεία που να στοιχειοθετούν μεγάλη αύξηση ή σοβαρή έξαρση των μυκητιάσεων που οφείλονται σε Candida auris. Καλό είναι να παραμένουμε ψύχραιμοι και να ακολουθούμε τις συμβουλές των ειδικών. Η τήρηση των βασικών κανόνων υγιεινής και η σχολαστική καθαριότητα των χώρων, όπου κινούμαστε είναι τα πιο αποτελεσματικά μέτρα προστασίας και πρόληψης για κάθε λοίμωξη.
Τα μέτρα που πρέπει να ακολουθούμε
Πλένουμε τακτικά και σχολαστικά τα χέρια μας, με σαπούνι και νερό και ακολούθως με αλκοολούχο διάλυμα, ιδίως πριν το φαγητό και μετά την τουαλέτα.
Απολυμαίνουμε τακτικά τα χέρια μας με αλκοολούχο διάλυμα, εάν δεν έχουμε πρόσβαση σε σαπούνι και νερό.
Καθαρίζουμε και απολυμαίνουμε σχολαστικά τις επιφάνειες των χώρων όπου ζούμε και εργαζόμαστε.
Σύμφωνα με τα διαθέσιμα δεδομένα, το χλώριο είναι αποτελεσματικό στην καταπολέμηση του Candida auris.
Χώροι φροντίδας βρεφών, παιδιών και υπερηλίκων, καθώς και ασθενών, όπως τα νοσοκομεία, οφείλουν να ακολουθούν τα ειδικά πρωτόκολλα καθαριότητας και απολύμανσης.
Εφόσον διαγνωσθεί μυκητίαση με Candida auris σε μη νοσηλευόμενο ασθενή, θα πρέπει να γίνει πλήρης και ακριβής ταυτοποίηση του μύκητα, καθώς και αντιμυκητόγραμμα, το οποίο δείχνει την ευαισθησία του μύκητα στα διαθέσιμα φάρμακα. Σε κάθε περίπτωση θα πρέπει να ακολουθούνται πιστά οι οδηγίες του θεράποντα ιατρού.

Δεν υπάρχουν σχόλια:
Δημοσίευση σχολίου